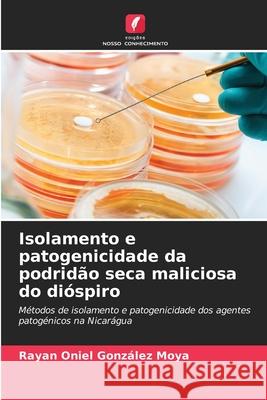
Isolamento e patogenicidade da podridão seca maliciosa do dióspiro González Moya, Rayan Oniel 9786208763831 Edições Nosso Conhecimento - książka

Isolamento e patogenicidade da podridão seca maliciosa do dióspiro » książka
topmenu
Isolamento e patogenicidade da podridão seca maliciosa do dióspiro
ISBN-13: 9786208763831 / Portugalski / Miękka / 2025 / 60 str.
Kategorie BISAC:
Wydawca:
Edições Nosso Conhecimento
Język:
Portugalski
ISBN-13:
9786208763831
Rok wydania:
2025
Ilość stron:
60
Wymiary:
22.0 x 15.0
Oprawa:
Miękka